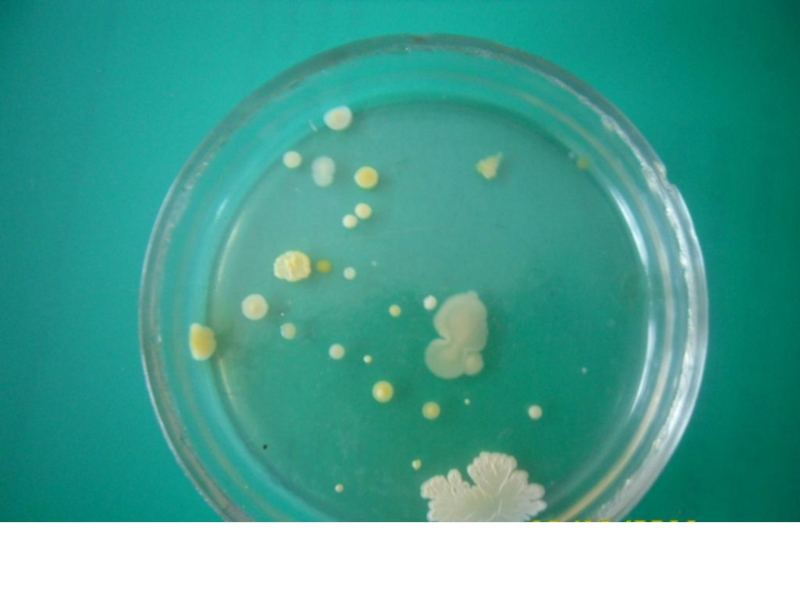

- Главная
- Разное
- Образование
- Спорт
- Естествознание
- Природоведение
- Религиоведение
- Французский язык
- Черчение
- Английский язык
- Астрономия
- Алгебра
- Биология
- География
- Геометрия
- Детские презентации
- Информатика
- История
- Литература
- Математика
- Музыка
- МХК
- Немецкий язык
- ОБЖ
- Обществознание
- Окружающий мир
- Педагогика
- Русский язык
- Технология
- Физика
- Философия
- Химия
- Шаблоны, фоны, картинки для презентаций
- Экология
- Экономика
Презентация, доклад исследовательской работы влияние эфирных масел на микрофлору закрытых помещений
Содержание
- 1. Презентация исследовательской работы влияние эфирных масел на микрофлору закрытых помещений
- 2. задачи:изучить биологический состав воздухаознакомиться с методами исследования
- 3. Актуальность проблемы стала понятна после того, как
- 4. Прежде всего, мы выяснили, что же собой
- 5. Эфирные масла –
- 6. Терпены и терпеноидыТерпе́ны — класс углеводородов —
- 7. Ароматограмма – это метод исследования антибактеральной силы
- 8. Одним из методов микробиологического исследования воздуха является
- 9. Затем чашки
- 10. Обработка результатов работыПодсчет числа колонийОпределение размеров колоний
- 11. Слайд 11
- 12. № 1, кабинет № 5 проба взятая сразу после уроков. Всего колоний 26
- 13. №2, кабинет №13 проба взятая после внеклассного мероприятия. Всего 20 колоний.
- 14. №3, кабинет №5 проба взятая после обработки
- 15. Результаты исследования Проделав работу по исследованию действия эфирных
- 16. Колонии микроорганизмовЧашка № 1, кабинет № 5
- 17. Колонии микроорганизмовЧашка №2, кабинет №13 проба взятая
- 18. Слайд 18
- 19. Слайд 19
- 20. Слайд 20
- 21. Слайд 21
- 22. Слайд 22
- 23. Слайд 23
- 24. Слайд 24
- 25. Слайд 25
- 26. Слайд 26
- 27. Выводы Мы добились решения поставленных задач. Нам удалось
Слайд 1Влияние эфирных масел на микрофлору воздуха закрытых помещений
Исследовательская работа по экологии
учащихся 10 класса
Яныбаева Рината
и Нуруллина Шамиля
Руководитель:
учитель химии:
Нажипова З.Ф.
Слайд 2задачи:
изучить биологический состав воздуха
ознакомиться с методами исследования микроорганизмов воздуха
изучить состав и
изучить химический состав эфирных масел.
ознакомиться с исследованиями в области ароматерапии
исследовать микрофлору воздуха в классах до и после обработки эфирными маслами
Цель работы :
доказать, что эфирные масла оказывают антисептическое действие на микрофлору воздуха закрытых помещений
Слайд 3Актуальность проблемы стала понятна после того, как мы изучили информацию о
Чем мы дышим
.
Слайд 4 Прежде всего, мы выяснили, что же собой представляют эфирные масла. Оказалось,
Большинство эфирных масел обладает противомикробным действием, большой бактерицидной активностью, активно подавляет рост гемолитических стафилококков, стрептококков, представителей тифо-дизентерийной группы и патогенных грибов. Мы решили провести свое исследование и проверить, действительно ли эфирные масла и фитонциды способны уничтожать патогенные микроорганизмы.
Слайд 5 Эфирные масла
– это сложные по химическому
Слайд 6Терпены и терпеноиды
Терпе́ны — класс углеводородов — продуктов биосинтеза общей формулы
Терпеноиды – окисленные формы терпенов, содержат кислород, углерод и водород. Они подразделяются на:
спирты;
альдегиды;
эфиры;
кетоны;
фенолы.
Слайд 7 Ароматограмма – это метод исследования антибактеральной силы эфирных масел.
Несколько серий
После инкубационного периода при температуре 37.5°C, измеряется ареол подавления, окружающий диски. Каждый ареол (цветное пятно) показывает разрушение патогенных микробов и дает четкое представление об антибактериальной деятельности использованных эфирных масел.
A - эфирное масло корицы (кора)
B - эфирное масло цитронеллы
C - эфирное масло эвкалипта шаровидного
D - эфирное масло эвкалипта лучистого
E - эфирное масло гвоздики
Слайд 8Одним из методов микробиологического исследования воздуха является метод оседания по Коху.
Мы провели исследования воздуха в каб.№5 и в каб.№13. Чашки Петри с питательным агаром открыли на 15 минут для осаждения бактерий из воздуха кабинетов. Далее обработали кабинет №5 - эфирным маслом базилика и кабинет №13 - чесноком. Затем чашки поставили на хранение в термостат при температуре 34 градуса. В качестве термостата использовали инкубатор «идеальная наседка». Через 3 суток провели подсчёт количества колоний в каждой и определили, сколько видов колоний в каждой чашке Петри. В чашках с пробами воздуха после обработки оказалось гораздо меньше колоний.
Слайд 9 Затем чашки закрыли и поставили на хранение в термостат при температуре
Через 3 суток провели подсчёт количества колоний в каждой и определили, сколько видов колоний в каждой чашке Петри.
В чашках с пробами воздуха после обработки кабинетов оказалось гораздо меньше колоний.
Слайд 14№3, кабинет №5 проба взятая после обработки чесноком. Всего колоний 8
№4,
Слайд 15Результаты исследования
Проделав работу по исследованию действия эфирных масел на микрофлору воздуха
в первой пробе оказалось очень много колоний микроорганизмов – 26, и они принадлежат 11 разным видам организмов. К такому выводу мы пришли изучая внешний вид колоний. Мы не ставили своей задачей определить видовую принадлежность микроорганизмов, образовавших данные колонии, поэтому считаем, что поставленная задача на данном этапе выполнена.
Во второй пробе оказалось 20 колоний, предположительно 9 видов микроорганизмов.
В третьей пробе (обработка чесноком) колоний оказалось всего 8 против 26 в первой пробе, что говорит об антимикробном действии фитонцидов чеснока.
В четвертой пробе (эфирное масло базилика) образовалось всего 5 колоний против 20 во второй пробе. Значит эфирное масло базилика также обладает очень мощным антимикробным действием.
Слайд 16Колонии микроорганизмов
Чашка № 1, кабинет № 5 проба взятая сразу после
Чашка №3, кабинет №5 проба взятая после обработки чесноком. Всего колоний 8
Слайд 17Колонии микроорганизмов
Чашка №2, кабинет №13 проба взятая после внеклассного мероприятия. Всего
Чашка№4, кабинет № 13 проба после обработки эфирным маслом базилика. Всего колоний 5.
Слайд 27Выводы
Мы добились решения поставленных задач. Нам удалось доказать, что эфирные масла
базилик
чеснок